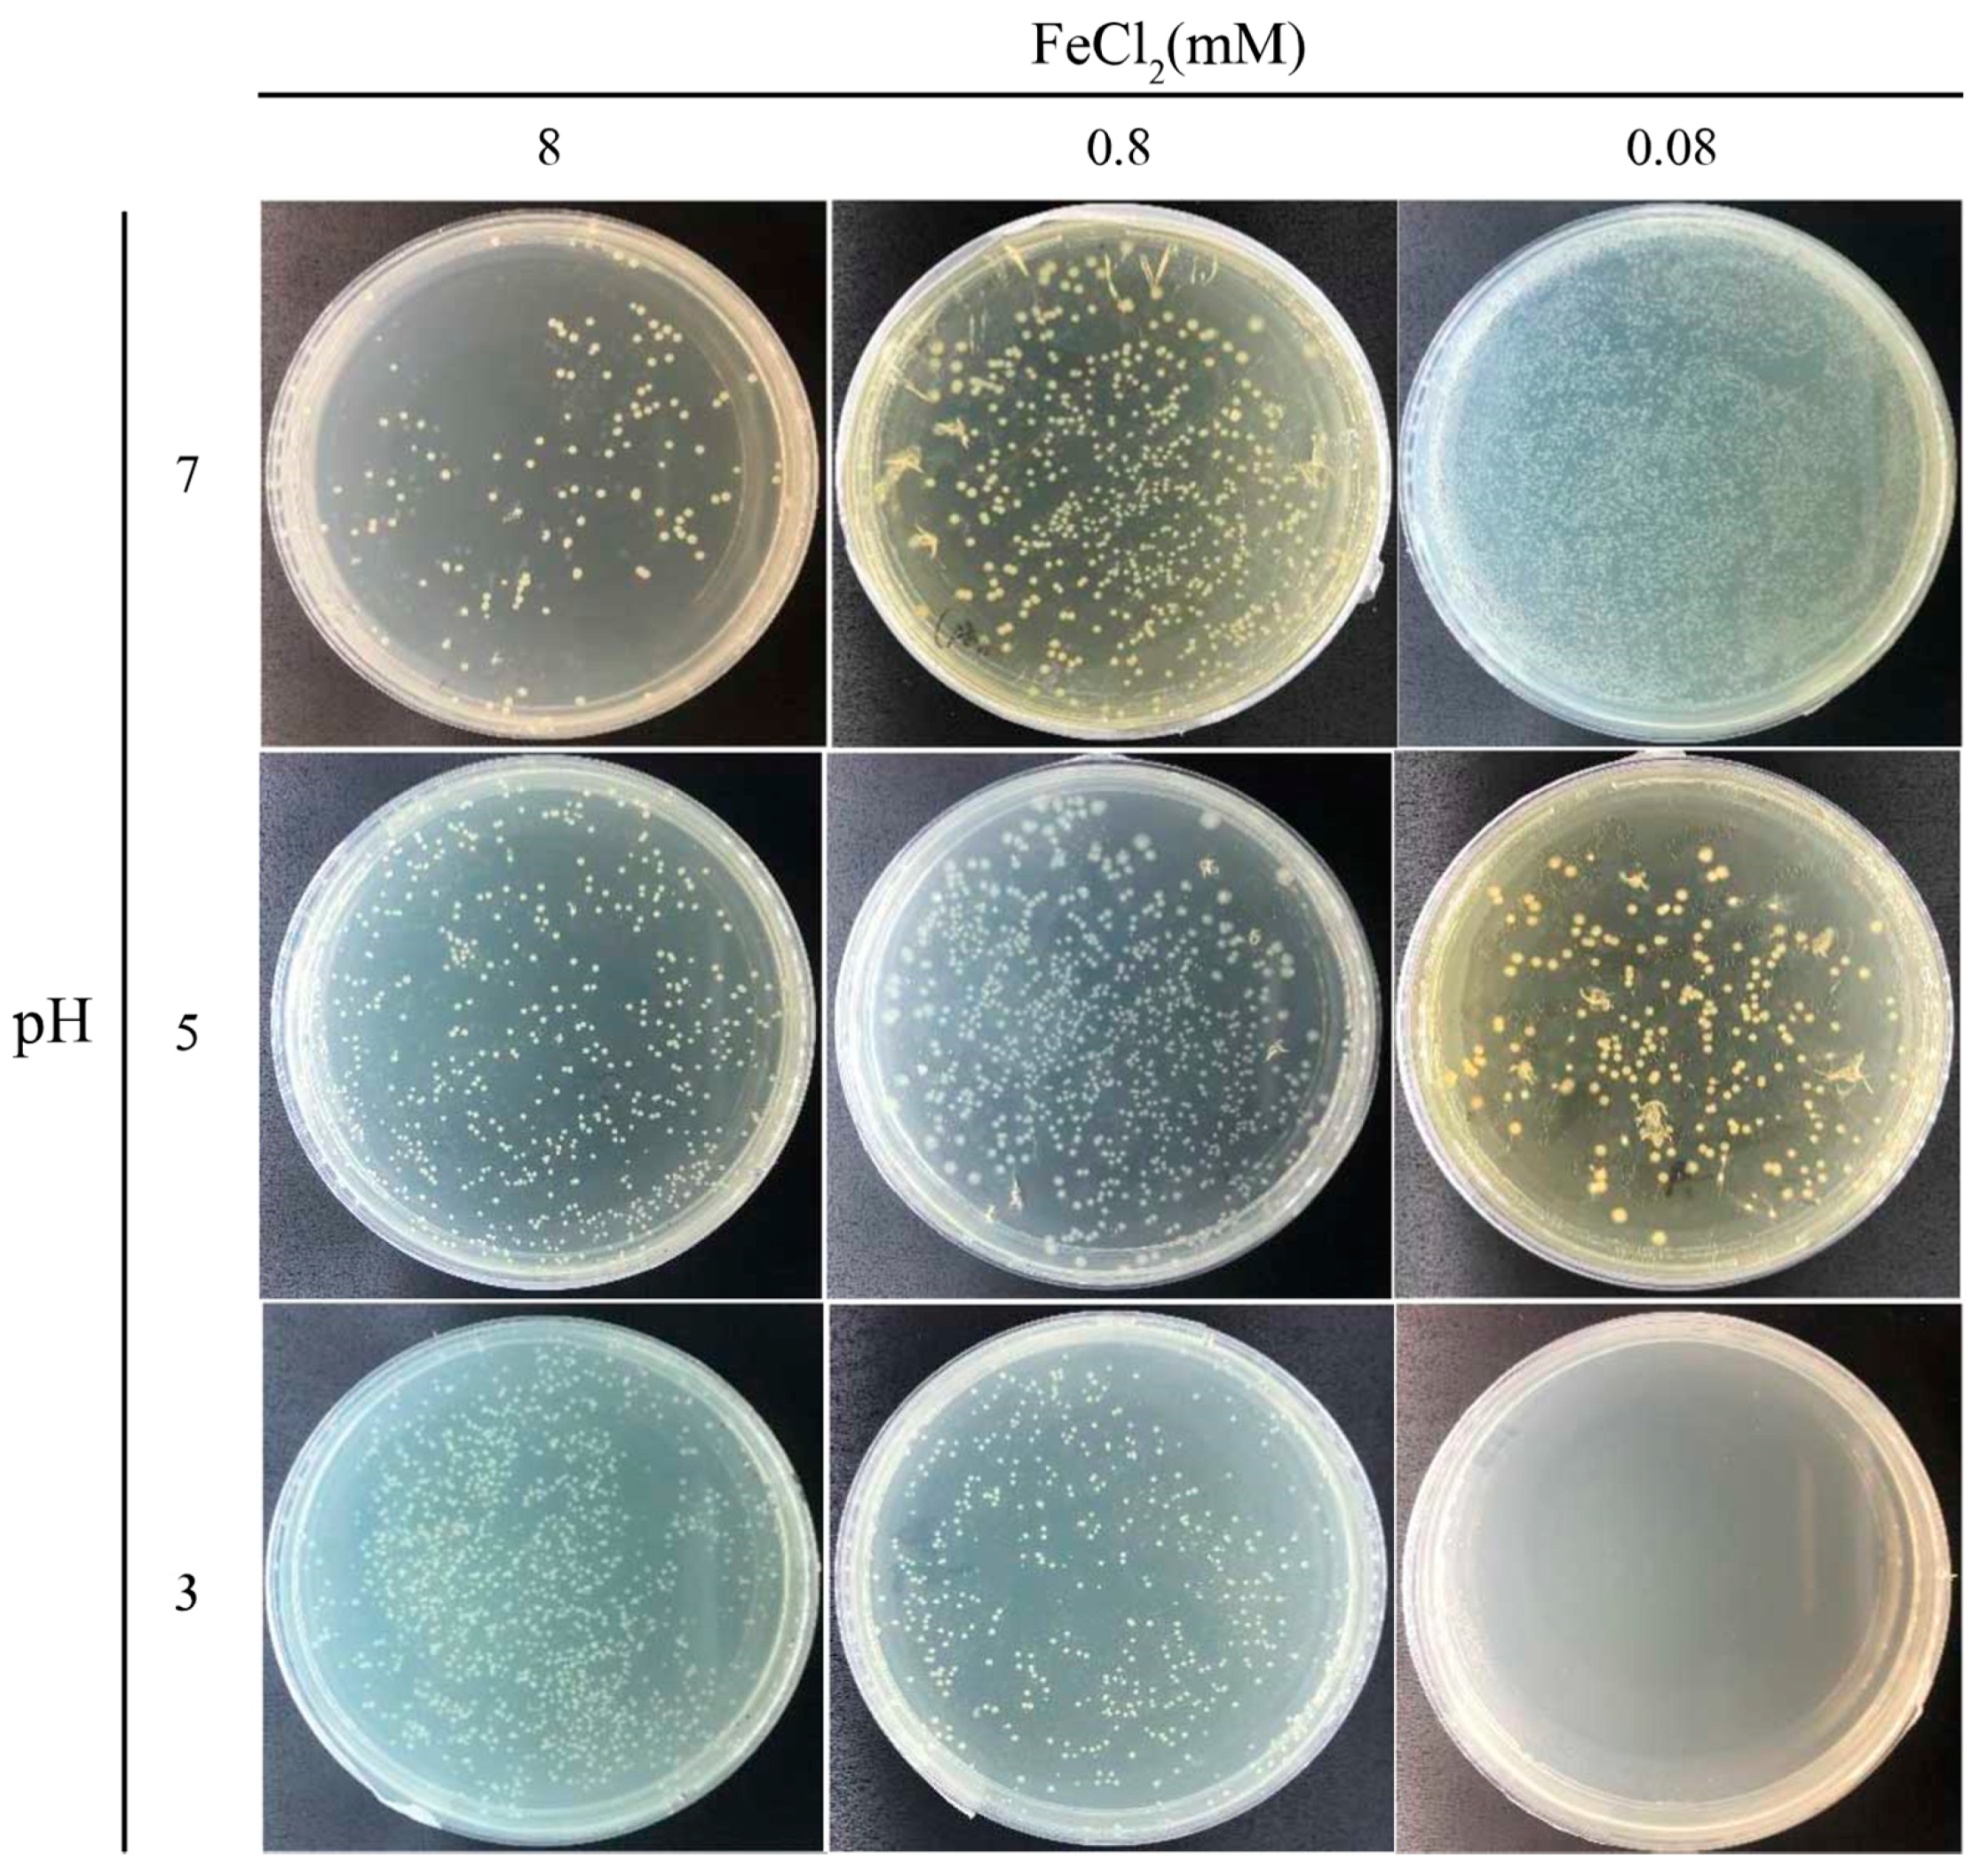
Microorganisms 09 00331 g005 Microorganisms 09 00331 g005

Precipitation of Magnetic Iron Oxide Induced by Sporosarcina pasteurii Cells
Abstract
1. Introduction
2. Materials and Methods
2.1. Strain and Culture Conditions
2.2. Magnetic MIP Induced by S. pasteurii Cells
2.3. Determination of the FeCl2 Concentration Using the 5-Sulfosalicylic Acid (SSA) Method
2.4. Optical Microscopy and Scanning Electron Microscope (SEM) Analysis
2.5. Microbial Activity Assay after MIP
3. Results
3.1. Magnetic MIP Induced by Cells of S. pasteurii
3.2. Characterization of the Magnetic MIP
3.3. Viability of Cells Covered with the Magnetic Precipitates
4. Discussion
5. Conclusions
Supplementary Materials
Author Contributions
Funding
Institutional Review Board Statement
Informed Consent Statement
Data Availability Statement
Conflicts of Interest
References
- Hsu, C.-M.; Huang, Y.-H.; Chen, H.-J.; Lee, W.-C.; Chiu, H.-W.; Maity, J.P.; Chen, C.-C.; Kuo, Y.-H.; Chen, C.-Y. Green synthesis of nano-Co3O4 by Microbial Induced Precipitation (MIP) process using Bacillus pasteurii and its application as supercapacitor. Mater. Today Commun. 2018, 14, 302–311. [Google Scholar] [CrossRef]
- Picard, A.; Gartman, A.; Clarke, D.; Girguis, P. Sulfate Reduction and Sulfide Biomineralization by Deep-Sea Hydrothermal Vent Microorganisms. In Proceedings of the AGU Fall Meeting Abstracts, San Francisco, CA, USA, 15–19 December 2014. [Google Scholar]
- Bernardi, D.; DeJong, J.; Montoya, B.; Martinez, B. Bio-bricks: Biologically cemented sandstone bricks. Constr. Build. Mater. 2014, 55, 462–469. [Google Scholar] [CrossRef]
- Wiktor, V.; Jonkers, H.M. Quantification of crack-healing in novel bacteria-based self-healing concrete. Cem. Concr. Compos. 2011, 33, 763–770. [Google Scholar] [CrossRef]
- Wang, Z.; Zhang, N.; Cai, G.; Jin, Y.; Ding, N.; Shen, D. Review of ground improvement using microbial induced carbonate precipitation (MICP). Mar. Georesour. Geotechnol. 2017, 35, 1135–1146. [Google Scholar] [CrossRef]
- Abduolrahimi, S.; Ghorbanzadeh, N.; Forghani, A.; Farhangi, M. Bioremediation of cadmium in contaminated sandy soil by microbially induced calcite precipitation. J. Water Soil 2018, 32, Pe343–Pe357. [Google Scholar]
- Benzerara, K.; Skouri-Panet, F.; Li, J.; Férard, C.; Gugger, M.; Laurent, T.; Couradeau, E.; Ragon, M.; Cosmidis, J.; Menguy, N. Intracellular Ca-carbonate biomineralization is widespread in cyanobacteria. Proc. Natl. Acad. Sci. USA 2014, 111, 10933–10938. [Google Scholar] [CrossRef]
- Ghaemi, N.; Madaeni, S.S.; Daraei, P.; Rajabi, H.; Zinadini, S.; Alizadeh, A.; Heydari, R.; Beygzadeh, M.; Ghouzivand, S. Polyethersulfone membrane enhanced with iron oxide nanoparticles for copper removal from water: Application of new functionalized Fe3O4 nanoparticles. Chem. Eng. J. 2015, 263, 101–112. [Google Scholar] [CrossRef]
- Owusu, K.A.; Qu, L.; Li, J.; Wang, Z.; Zhao, K.; Yang, C.; Hercule, K.M.; Lin, C.; Shi, C.; Wei, Q. Low-crystalline iron oxide hydroxide nanoparticle anode for high-performance supercapacitors. Nat. Commun. 2017, 8, 14264. [Google Scholar] [CrossRef] [PubMed]
- Allia, P.; Barrera, G.; Tiberto, P.; Nardi, T.; Leterrier, Y.; Sangermano, M. Fe3O4 nanoparticles and nanocomposites with potential application in biomedicine and in communication technologies: Nanoparticle aggregation, interaction, and effective magnetic anisotropy. J. Appl. Phys. 2014, 116, 113903. [Google Scholar] [CrossRef]
- Schwaminger, S.P.; Fraga-García, P.; Blank-Shim, S.A.; Straub, T.; Haslbeck, M.; Muraca, F.; Dawson, K.A.; Berensmeier, S. Magnetic One-Step Purification of His-Tagged Protein by Bare Iron Oxide Nanoparticles. ACS Omega 2019, 4, 3790–3799. [Google Scholar] [CrossRef] [PubMed]
- Bharde, A.; Wani, A.; Shouche, Y.; Joy, P.A.; Prasad, B.L.; Sastry, M. Bacterial aerobic synthesis of nanocrystalline magnetite. J. Am. Chem. Soc. 2005, 127, 9326–9327. [Google Scholar] [CrossRef]
- Bharde, A.A.; Parikh, R.Y.; Baidakova, M.; Jouen, S.; Hannoyer, B.; Enoki, T.; Prasad, B.L.; Shouche, Y.S.; Ogale, S.; Sastry, M. Bacteria-mediated precursor-dependent biosynthesis of superparamagnetic iron oxide and iron sulfide nanoparticles. Langmuir ACS J. Surf. Colloids 2008, 24, 5787–5794. [Google Scholar] [CrossRef]
- Presentato, A.; Piacenza, E.; Turner, R.J.; Zannoni, D.; Cappelletti, M. Processing of Metals and Metalloids by Actinobacteria: Cell Resistance Mechanisms and Synthesis of Metal(loid)-Based Nanostructures. Microorganisms 2020, 8, 2027. [Google Scholar] [CrossRef] [PubMed]
- Maass, D.; de Medeiros Machado, M.; Rovaris, B.C.; Bernardin, A.M.; de Oliveira, D.; Hotza, D. Biomining of iron-containing nanoparticles from coal tailings. Appl. Microbiol. Biotechnol. 2019, 103, 7231–7240. [Google Scholar] [CrossRef] [PubMed]
- Maass, D.; Valério, A.; Lourenço, L.A.; de Oliveira, D.; Hotza, D. Biosynthesis of iron oxide nanoparticles from mineral coal tailings in a stirred tank reactor. Hydrometallurgy 2019, 184, 199–205. [Google Scholar] [CrossRef]
- Shi, H.; Tan, L.; Du, Q.; Chen, X.; Li, L.; Liu, T.; Fu, C.; Liu, H.; Meng, X. Green synthesis of Fe3O4 nanoparticles with controlled morphologies using urease and their application in dye adsorption. Dalton Trans. 2014, 43, 12474–12479. [Google Scholar] [CrossRef] [PubMed]
- Karamanev, D.G.; Nikolov, L.N.; Mamatarkova, V. Rapid simultaneous quantitative determination of ferric and ferrous ions in drainage waters and similar solutions. Min. Eng. 2002, 15, 341–346. [Google Scholar] [CrossRef]
- Whiffin, V.S. Microbial CaCO3 Precipitation for the Production of Biocement. Ph.D. Thesis, Murdoch University, Murdoch, WA, Australian, 2004. [Google Scholar]
- Moosazadeh, R.; Tabandeh, F.; Kalantari, F.; Yazdian, F. Efficacy of Fe3O4/Starch Nanoparticles on Sporosarcina pasteurii Performance in MICP Process. Geomicrobiol. J. 2019, 36, 359–365. [Google Scholar] [CrossRef]

Publisher’s Note: MDPI stays neutral with regard to jurisdictional claims in published maps and institutional affiliations. |
© 2021 by the authors. Licensee MDPI, Basel, Switzerland. This article is an open access article distributed under the terms and conditions of the Creative Commons Attribution (CC BY) license (http://creativecommons.org/licenses/by/4.0/).
Share and Cite
Wu, Y.; Zhao, G.; Qi, H. Precipitation of Magnetic Iron Oxide Induced by Sporosarcina pasteurii Cells. Microorganisms 2021, 9, 331. https://doi.org/10.3390/microorganisms9020331
Wu Y, Zhao G, Qi H. Precipitation of Magnetic Iron Oxide Induced by Sporosarcina pasteurii Cells. Microorganisms. 2021; 9(2):331. https://doi.org/10.3390/microorganisms9020331
Chicago/Turabian StyleWu, Yang, Guozheng Zhao, and Hao Qi. 2021. "Precipitation of Magnetic Iron Oxide Induced by Sporosarcina pasteurii Cells" Microorganisms 9, no. 2: 331. https://doi.org/10.3390/microorganisms9020331
APA StyleWu, Y., Zhao, G., & Qi, H. (2021). Precipitation of Magnetic Iron Oxide Induced by Sporosarcina pasteurii Cells. Microorganisms, 9(2), 331. https://doi.org/10.3390/microorganisms9020331

